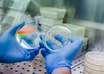

A single dose of methylphenidate does not affect the contextual visual perception of children with ADHD, shows study
MedicalXpress Breaking News-and-Events | Feb 25, 2023
Pfizer cites positive results on migraine treatment
MedicalXpress Breaking News-and-Events | Feb 18, 2023
Antidepressants use for chronic pain on the rise, but are they effective?
MedicalXpress Breaking News-and-Events | Feb 03, 2023
Research links gene variants to medication-induced fatal brain infection
MedicalXpress Breaking News-and-Events | Dec 15, 2022
Psilocybin-assisted psychotherapy may effectively treat alcohol use disorder
MDlinx | Oct 18, 2022
Pace as important as 10,000 steps for health, finds new research
MedicalXpress Breaking News-and-Events | Sep 14, 2022
Establishing a novel strategy to tackle Huntington's disease
ScienceDaily | Sep 08, 2022
Stem cell-gene therapy shows promise in ALS safety trial
MedicalXpress Breaking News-and-Events | Sep 07, 2022
Which leisure activities are linked to lower risk of dementia?
MedicalXpress Breaking News-and-Events | Aug 12, 2022
'Good evidence' that ADHD drugs might also treat Alzheimer's disease
MedicalXpress Breaking News-and-Events | Jul 07, 2022